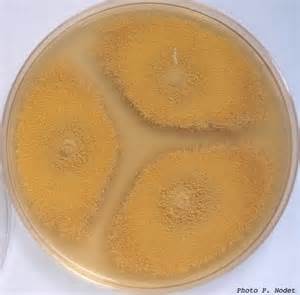
赭曲霉

点曲霉

吃出个肝癌一种食物最好别吃开水煮不死还滋养癌细胞
图片尺寸1000x750
丝状真菌杂色曲霉
图片尺寸1080x1439
黄曲霉毒素生存地点
图片尺寸1080x720
青霉和曲霉的区别有什么
图片尺寸1024x576
自己拍的曲霉图片请欣赏
图片尺寸850x766
曲霉的有性孢子 曲霉的孢子是什么形状?-图片大观-奇异网
图片尺寸634x1130
家里几处地方,是黄曲霉素的"温床",为健康着想
图片尺寸600x449
黄曲霉毒素,这个鲜为人知的名词,却隐藏在我们日常
图片尺寸640x427
曲霉图片
图片尺寸450x300
1毫克就能致癌20毫克就能致命发霉食物中的黄曲霉素
图片尺寸939x505
赭曲霉
图片尺寸300x295
曲块上的小白点
图片尺寸575x528
干货曲霉辨识心得
图片尺寸613x1280
本文将带你深入了解黄曲霉菌的危害性,并提供防范
图片尺寸640x960
解决方案_来宝商城
图片尺寸500x381
除此之外,发霉食物中还有杂色曲霉毒素,赭曲霉毒素等,它们都有较强的
图片尺寸900x500
误食黄曲霉素一毫克就致癌?哪些常见物品容易滋生黄曲霉素?
图片尺寸640x427
真菌大讲堂拾零(七)曲霉篇
图片尺寸1080x1080
棉铃曲霉病
图片尺寸542x356
霉: 黄曲霉毒素,你还不躲它远点 花生,玉米等食物很容易受潮,进而
图片尺寸750x319